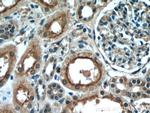
PDE2A Antibody in Immunohistochemistry (Paraffin) (IHC (P))
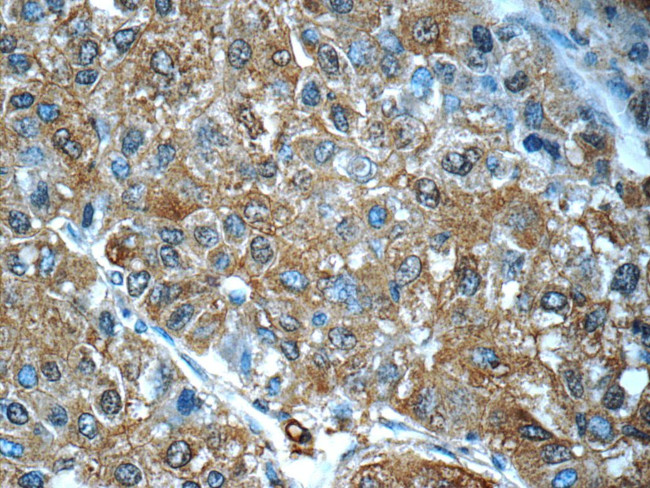
PDE2A Antibody in Immunohistochemistry (Paraffin) (IHC (P))

Search
Proteintech
PDE2A Polyclonal Antibody
{{$productOrderCtrl.translations['antibody.pdp.commerceCard.promotion.promotions']}}
{{$productOrderCtrl.translations['antibody.pdp.commerceCard.promotion.viewpromo']}}
{{$productOrderCtrl.translations['antibody.pdp.commerceCard.promotion.promocode']}}: {{promo.promoCode}} {{promo.promoTitle}} {{promo.promoDescription}}. {{$productOrderCtrl.translations['antibody.pdp.commerceCard.promotion.learnmore']}}

Please note: We are reviewing Western blot images included in the antibody testing data in our catalog, including those provided by third parties. Unless expressly labeled or annotated as “raw-unedited”, Western blot images included in the antibody testing data in our catalog may have been edited, optimized or otherwise adjusted for presentation.
产品信息
55306-1-AP
种属反应
已发表种属
宿主/亚型
分类
类型
抗原
偶联物
形式
浓度
规格
纯化类型
保存液
内含物
保存条件
运输条件
产品详细信息
This antibody is specific to PDE2A.
靶标信息
PDE2A (phosphodiesterase 2A) is a 100 kD cyclic nucleotide phosphodiesterase (PDE) and three isoforms of PDE2A have been reported (PDE2A1, PDE2A2 and PDE2A3) which arise from a single gene by alternative splicing events. PDE2A can degrade both cAMP and cGMP, but degrades cGMP with greater efficacy. PDE2A is expressed in a variety of tissue types, with greatest expression in the brain, where it is localized in the cerebellum and neocortex. PDE2A has been implicated in penile erectile dysfunction and in the regulation of fluid and inflammatory cell transport across the endothelial cell barrier.
仅用于科研。不用于诊断过程。未经明确授权不得转售。
生物信息学
蛋白别名: cGMP-dependent 3',5'-cyclic phosphodiesterase; CGS-PDE; cGSPDE; cyclic GMP stimulated phosphodiesterase; Cyclic GMP-stimulated phosphodiesterase
基因别名: CGS-PDE; cGSPDE; Pde2; PDE2A; Pde2a2
UniProt ID: (Rat) Q01062, (Mouse) Q922S4
Entrez Gene ID: (Rat) 81743, (Mouse) 207728